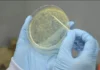
Pesquisa utiliza fungos promotores de energia renovável para agricultura, construções e biocombustíveis fungos

O desmatamento na Caatinga, bioma exclusivamente brasileiro, atingiu em 2025 um de seus episódios mais alarmantes. Entre novembro do ano passado e fevereiro deste ano, uma única fazenda situada nos municípios piauienses de Canto do Buriti e Pavussu derrubou 13,7 mil hectares de vegetação nativa em apenas três meses. O dado, revelado em abril pelo MapBiomas, representa o maior registro desde o início do monitoramento, em 2019.

Embora a área possua autorização emitida pela Secretaria de Meio Ambiente e Recursos Hídricos do Piauí (Semarh), imagens de satélite analisadas pela geógrafa Débora Lima, pesquisadora da Universidade de São Paulo (USP) e integrante do grupo de Estudos Críticos do Desenvolvimento Rural do Conselho Latino-Americano de Ciências Sociais (CLACSO), mostram que o desmate já ultrapassou os 30 mil hectares. O salto equivale a devastar uma área pouco maior que a capital mineira, Belo Horizonte, ou transformar em pasto o equivalente a 43 mil campos de futebol.
Esse processo está diretamente ligado à expansão da agropecuária intensiva e ao avanço de projetos de energia solar e eólica, que se tornaram motores adicionais de pressão sobre a Caatinga. No caso específico do Piauí, documentos obtidos pela reportagem indicam que a fazenda prepara espaço para a criação de 43 mil cabeças de gado.
Fantasmas da Boi Gordo
O desmatamento recorde traz de volta o nome da Fazendas Reunidas Boi Gordo, grupo que protagonizou um dos maiores escândalos financeiros do Brasil nos anos 2000. A empresa, criada com a promessa de ganhos rápidos por meio de cotas em rebanhos e terras, quebrou em 2004 e deixou um rombo de cerca de R$ 4 bilhões, atingindo mais de 32 mil investidores.
Na massa falida, relatórios apontaram que propriedades públicas e privadas vinculadas à Boi Gordo foram repassadas irregularmente a terceiros próximos ao grupo, muitas vezes sem registro válido ou com documentação forjada. Entre os nomes associados a essas transferências aparece o da gaúcha Maribel Schmittz Golin, hoje relacionada à exploração de terras na metade sul do Piauí, incluindo a área atualmente desmatada.
O Ministério Público de São Paulo, estado onde a Boi Gordo foi registrada, e o Ministério Público do Piauí chegaram a investigar fraudes, grilagem e desvio de imóveis da massa falida. Algumas propriedades tiveram os registros bloqueados pelo Instituto Nacional de Colonização e Reforma Agrária (Incra), por apresentarem documentos invalidados. Apesar disso, parte das terras segue em uso privado, alimentando novos ciclos de devastação.

SAIBA MAIS: Este pequeno roedor da caatinga tem uma tática genial de sobrevivência
Uma Caatinga sob risco
O caso no Piauí é apenas a face mais visível de um fenômeno mais amplo. Segundo o MapBiomas, a Caatinga perdeu 9,25 milhões de hectares de vegetação nativa nos últimos 40 anos, equivalente a 14% de sua cobertura original. É como se uma área do tamanho de Portugal tivesse sido devastada, com impactos severos para os ecossistemas semiáridos, já vulneráveis às mudanças climáticas.
As causas principais são a expansão da fronteira agropecuária e, mais recentemente, a implantação acelerada de usinas solares e eólicas. Embora essas fontes de energia sejam vistas como alternativas limpas, sua instalação em áreas sensíveis, sem planejamento socioambiental adequado, pode gerar novos conflitos fundiários e ecológicos.
Em paralelo, operações do governo piauiense têm tentado frear a destruição. Só em 2025, até o fechamento desta reportagem, foram aplicados R$ 23 milhões em multas por crimes ambientais em municípios como Cajueiro da Praia, Milton Brandão, Bom Jesus e Currais. Segundo José Renato Araújo Nogueira, gerente de Fiscalização da Semarh, a repressão só é possível porque as equipes trabalham com imagens de satélite constantemente atualizadas.
O nó da regularização
Para a especialista Débora Lima, o avanço da fronteira agropecuária e energética no semiárido coloca em risco as metas climáticas do Brasil e expõe a fragilidade dos instrumentos de regulação. Ela aponta que o Cadastro Ambiental Rural (CAR) no Piauí apresenta falhas como sobreposição de áreas, baixa validação e pouca transparência sobre reservas legais e Áreas de Preservação Permanente.
Um painel federal confirma que, no estado, apenas 108 cadastros tiveram a análise de regularidade ambiental concluída até agora — número insignificante diante da extensão da fronteira agrícola. Sem uma base sólida de dados, as fiscalizações ficam comprometidas e a chance de fraudes e grilagens aumenta.
O desmatamento recorde na Caatinga escancara como o vácuo de governança fundiária se converte em terreno fértil para velhos e novos atores do capital extrativista. O fantasma da Boi Gordo, que arruinou milhares de investidores e se apropriou de terras de forma questionável, volta a assombrar o semiárido agora sob o rastro de tratores e correntões.
A pressão por carne, grãos e energia verde transforma a Caatinga em um bioma cada vez mais frágil, em um momento em que o mundo exige transições sustentáveis. Desviar dessa rota exige mais do que operações pontuais: pede reformas legais, fortalecimento de cadastros ambientais, transparência fundiária e alternativas produtivas que valorizem o território sem destruí-lo.